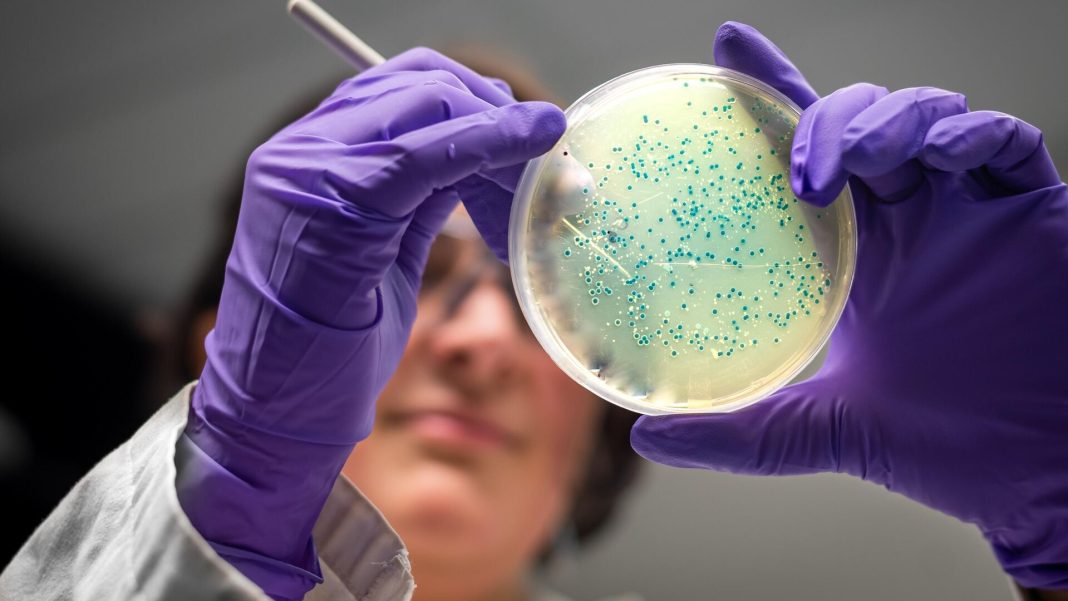

Дзен
МОСКВА, 13 декабря. Международная группа исследователей при участии Волгоградского государственного технического университета описала антибактериальные свойства препаратов из нескольких штаммов лактобацилл. Некоторые вещества, вырабатываемые микроорганизмами, оказались бактериоцинами — «природными» антибиотиками, опасными только для бактерий. По мнению специалистов, использование «живых» консервантов может стать альтернативой синтетическим антибиотикам, что положительно скажется на здоровье потребителей и окружающей среде. Результат представлен в разделе «Продукты питания».
В разные эпохи человечество использовало разные методы для продления срока годности продуктов питания и защиты их от патогенных организмов. Например, одними из «ранних» консервантов были раствор поваренной соли, «высушивающий» бактерии, винный уксус и молочная кислота.
С появлением химической промышленности началось производство синтетических веществ, препятствующих росту и развитию патогенных микроорганизмов. Сегодня такие пищевые добавки обозначаются как E2xx, рассказали специалисты Волгоградского государственного технического университета (Волгоградский государственный технический университет). При превышении допустимых объемов потребления некоторых соединений E2 у человека могут возникнуть побочные эффекты, затрагивающие желудочно-кишечный тракт, вызывающие аллергические реакции или влияющие на нервную систему, отметили ученые.
По словам экспертов, современное пищевое производство постепенно возвращается к концепции использования натуральных средств для продления срока годности продуктов. В основе этой концепции лежит добавление безопасных убитых микроорганизмов, способных вырабатывать бактериоцины — вещества, к которым другие бактерии еще не приспособились и не могут быть устойчивы, как к некоторым антибиотикам, подчеркивают исследователи.
Международная группа ученых при участии Волгоградского государственного технического университета обнаружила бактериоцины как продукты метаболизма у штаммов бактерии Latilactobacillus sakei (подвид sakei 2a) и установила их безопасность для небактериальных клеток. Этот микроорганизм часто присутствует в мясных продуктах и участвует в процессах ферментации, которые не только продлевают срок хранения мяса, но и улучшают его вкус и запах.
«Некоторые виды лактобацилл продуцируют факторы вирулентности — молекулы, губительные для соседних микроорганизмов. Latilactobacillus sakei — это именно тот вид, который выделяет бактериоцины, убивает другие микроорганизмы и использует их в пищу», — рассказала один из авторов исследования, декан факультета технологии пищевых производств Волгоградского государственного технического университета Валентина Храмова.
Эксперт добавил, что в современных продуктах питания консерванты добавляются вместе с антибиотиками, поэтому натуральный консервант должен быть устойчив к антимикробной активности. В рамках работы было установлено, что распространенные антибиотики амоксициллин и норфлоксацин не вредят Latilactobacillus sakei, а ванкомицин снижает численность этих организмов. Поэтому данный штамм можно рассматривать как основу для создания биоконсервантов.
Как отметила Храмова, ключевую роль в исследовании сыграл один из ведущих мировых ученых в области пробиотиков с антимикробными свойствами белков (бактериоцинов) и биоконсервации, профессор кафедры пищевых наук и экспериментального питания Университета Сан-Паулу Святослав Димитров Тодоров.
Ученые из России (Волгоградский государственный технический университет и ДГТУ), Бразилии (Университет Сан-Паулу), Болгарии (Софийский университет) и Португалии (Политехнический институт Виана-ду-Каштелу).
Часть работы была поддержана грантом Президента Российской Федерации.